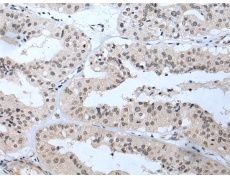
一抗

|
Background: |
This gene is a member of a phylogenetically conserved family of genes that share a common DNA-binding domain, the T-box. T-box genes encode transcription factors involved in the regulation of developmental processes. This gene product shares 98% amino acid sequence identity with the mouse ortholog. DiGeorge syndrome (DGS)/velocardiofacial syndrome (VCFS), a common congenital disorder characterized by neural-crest-related developmental defects, has been associated with deletions of chromosome 22q11.2, where this gene has been mapped. Studies using mouse models of DiGeorge syndrome suggest a major role for this gene in the molecular etiology of DGS/VCFS. Several alternatively spliced transcript variants encoding different isoforms have been described for this gene. |
|
Applications: |
ELISA, WB, IHC |
|
Name of antibody: |
TBX1 |
|
Immunogen: |
Synthetic peptide of human TBX1 |
|
Full name: |
T-box 1 |
|
Synonyms: |
DGS; TGA; VCF; CAFS; CTHM; DGCR; DORV; VCFS; TBX1C; CATCH22 |
|
SwissProt: |
O43435 |
|
ELISA Recommended dilution: |
5000-10000 |
|
IHC positive control: |
Human liver cancer |
|
IHC Recommend dilution: |
25-100 |
|
WB Predicted band size: |
43 kDa |
|
WB Positive control: |
293T and Hela cell lysates |
|
WB Recommended dilution: |
500-2000 |


 購物車
購物車 幫助
幫助
 021-54845833/15800441009
021-54845833/15800441009